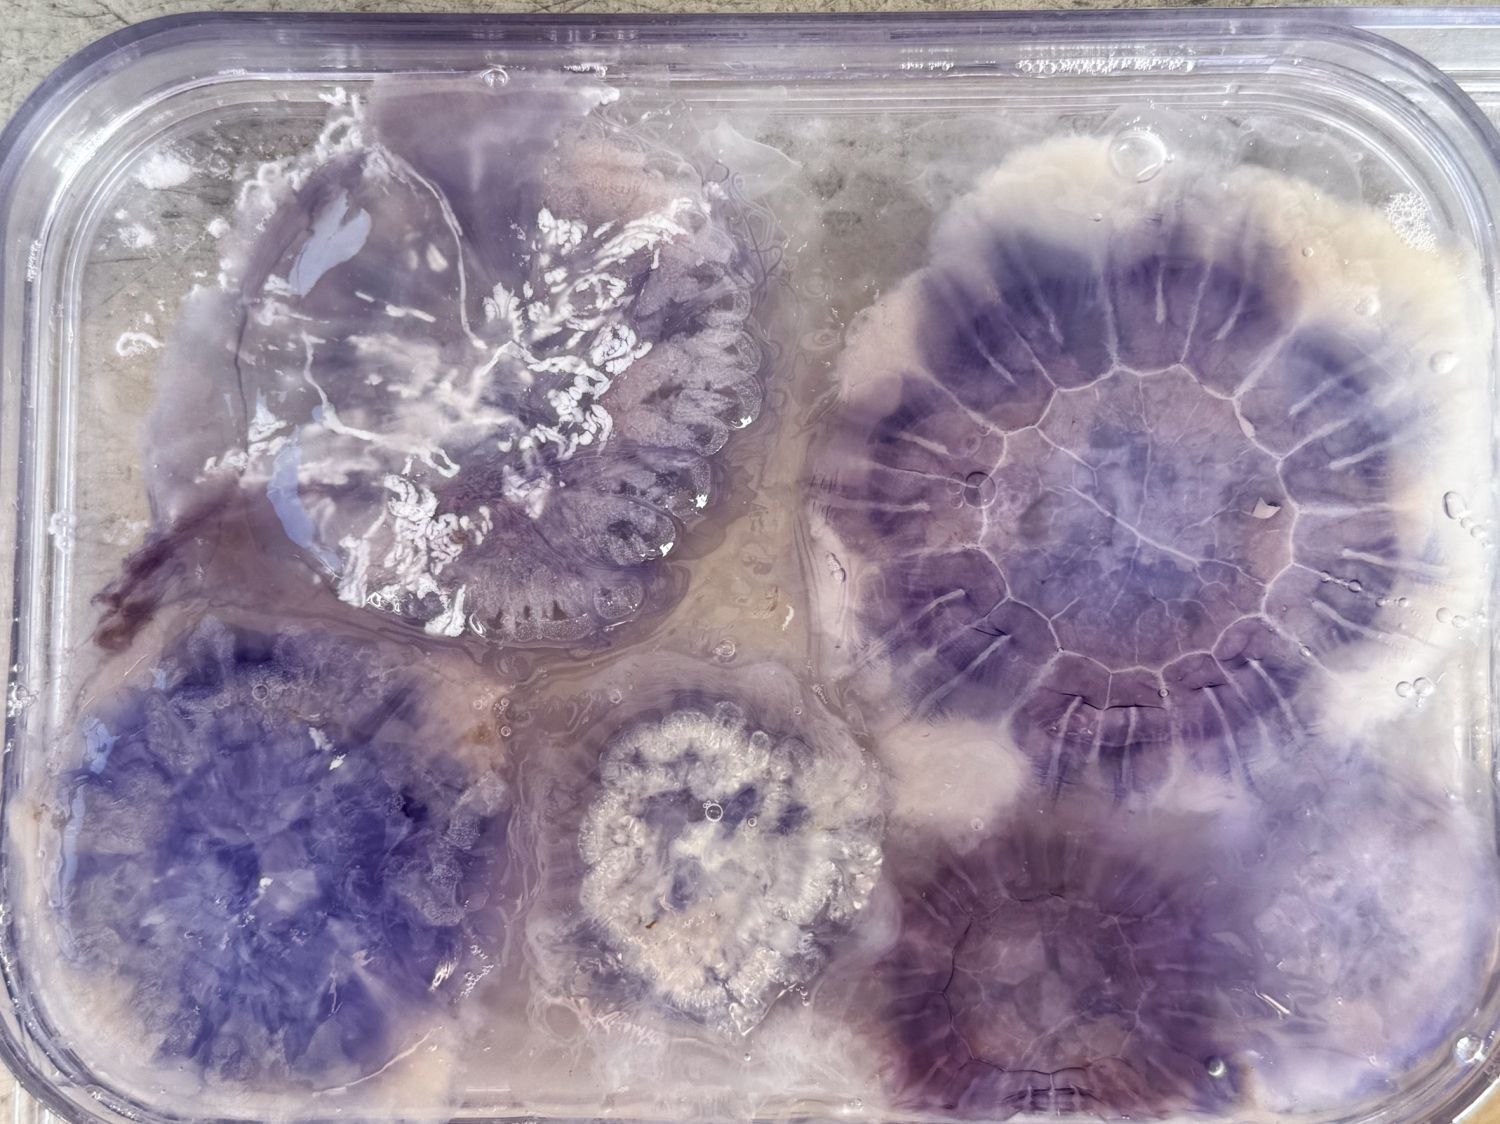

samedi 29 novembre 2025 – 17:30 Passé
Screening & Workbook Launch (en)
On Extraction, Relations and Care: Knowledge Production in Artistic–Scientific Processes
Kunsthaus Biel Centre d’art Bienne (KBCB) - Bienne
«Extraction, relations et bienveillance : production de connaissances dans les processus artistiques et scientifiques»
avec le groupe d’étude Relational Ecologies: Andrea Bordoli, Celestina Widmer, Jinat Hossain, Marta Musso, Nicolle Bussien and Riikka Tauriainen
Cet après-midi, le groupe d’étude Relational Ecologies présente quatre courts métrages, suivis d’une discussion collective. Le programme reflète la manière dont différentes approches de la production de connaissances influencent le travail artistique et scientifique, et examine les pratiques de soins, de collaboration et de méthodologie commune.
Le groupe d’étude est né d'un intérêt pour les écosystèmes relationnels et du besoin de formes d’échange durables et familières. Il offre un espace où la recherche est façonnée par l’apprentissage mutuel et l’imagination. Le groupe rassemble des chercheurs et des praticiens qui se concentrent sur l’anthropologie visuelle, l’écologie politique féministe, l’activisme écoféministe, les sciences marines et l’art.
Dans le cadre d’un projet communautaire sur le thème «Écosystèmes planctoniques», un cahier d’exercices a été élaboré, qui sera également présenté lors de cet événement. Il documente des processus artistiques et scientifiques et invite à approfondir la réflexion.
Qui : public intéressé par l’art, les sciences et l’écologie, praticien·nes
Coût : gratuit
Lieu : Filmpodium Biel/Bienne















